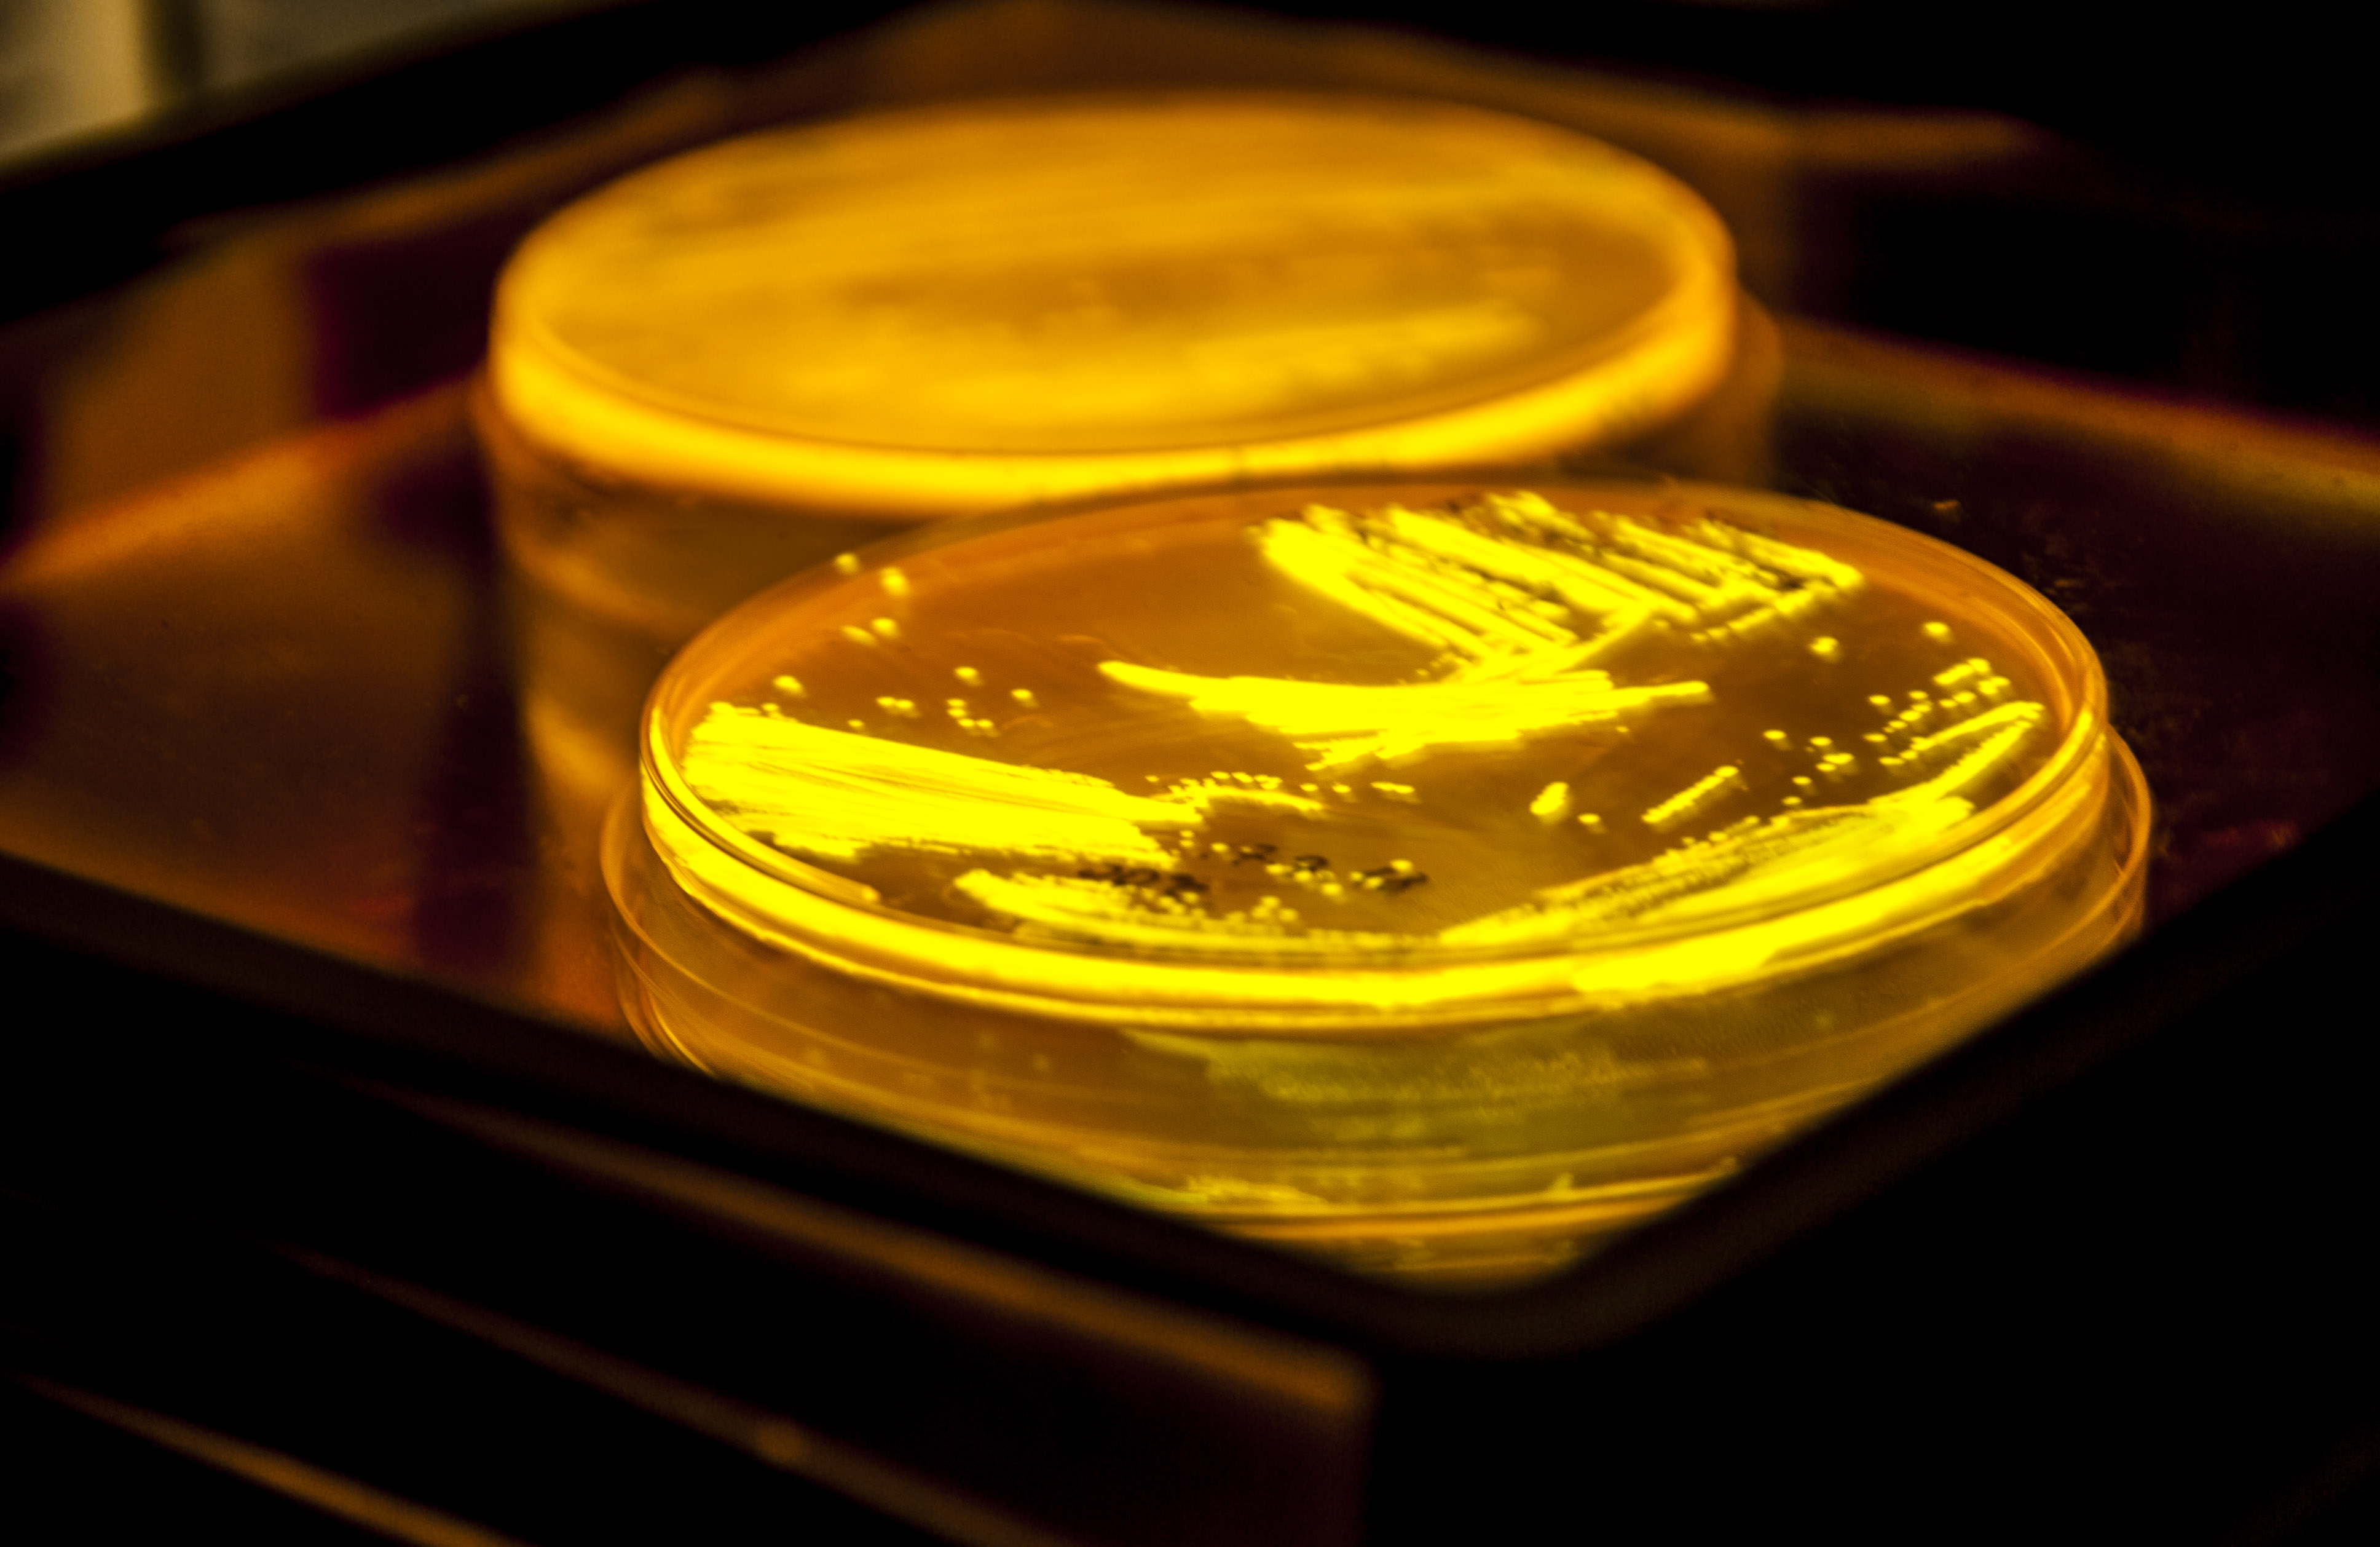

Plasmids
Published and available plasmids and vectors currently used in our lab.

Bioinformatic tools
Useful tools and data bases for Synthetic Biology and Metabolic Engineering.

Techniques
A set of optimized techniques used regularly on our lab.